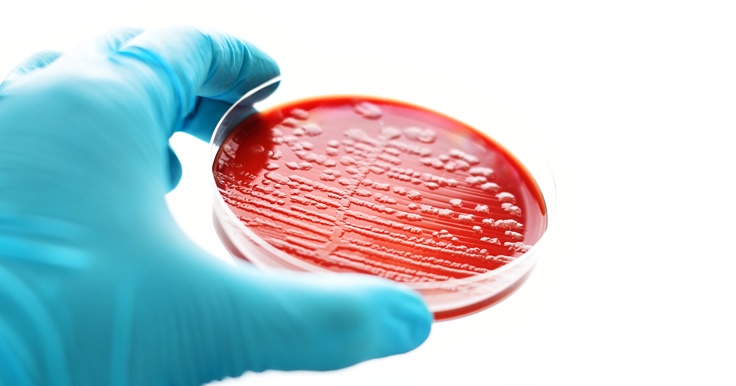

Madrid, 26 de agosto de 2019 – El Consejo General de Colegios Oficiales de Farmacéuticos quiere sumarse a las declaraciones que tanto el Ministerio de Sanidad, Consumo y Bienestar Social como las Organizaciones Colegiales de otras profesiones sanitarias han realizado en relación con el brote de listeriosis asociado al consumo de carne mechada.
En este sentido, manifestamos nuestro respaldo a las acciones, actuaciones y protocolos impulsado tanto por la Consejería de Salud y Familias de la Junta de Andalucía como por el Ministerio de Sanidad, Consumo y Bienestar Social. Consideramos que son adecuados y correctos para afrontar una situación como la generada por el consumo de carne mechada de la marca “La Mecha” contaminada por la bacteria listeria. Se trata de unos hechos que han puesto a prueba la capacidad de reacción del Sistema Nacional de Salud ante un caso de grave riesgo para la salud pública, ofreciendo una respuesta proporcionada a la situación generada.
El Consejo General de Farmacéuticos recuerda la necesidad de cumplir las medidas de precaución de las Autoridades Sanitarias, entre las que se encuentra la de abstenerse de consumir carne mechada de la marca “La Mecha” que se tenga en el domicilio, así como en caso de haberla consumido y presentar alguna sintomatología acudir a un centro sanitario.
La Organización Farmacéutica Colegial, como representante de los 74.000 farmacéuticos y de la red de las más de 22.000 farmacias repartidas por toda España, se pone a disposición de las Autoridades Sanitarias para colaborar en todo aquello que se estime necesario con el fin de abordar con la mayor eficacia posible este brote de listeriosis y reducir sus consecuencias sobre la población.
Lamentamos profundamente las muertes generadas por este brote de listeriosis y deseamos la pronta recuperación de todos los afectados. Del mismo modo, desde el Consejo General de Farmacéuticos agradecemos la labor desempeñada por todos los profesionales sanitarios que están trabajando y colaborando para atender a las personas que están sufriendo las consecuencias de este brote, así como para evitar la aparición de nuevos casos.
Por último, el Consejo General de Farmacéuticos queremos transmitir un mensaje de confianza y tranquilidad al conjunto de la sociedad en la seguridad de que las Autoridades Sanitarias y los profesionales sanitarios, están trabando con la máxima diligencia posible.
